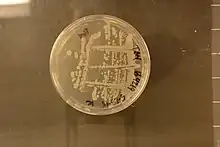

Bacillus subtilis subsp. subtilis
Taxonavigation
| Taxonavigation: Bacillales |
|---|
|
Prokaryota |
Familia: Bacillaceae
Genus: Bacillus
Species: Bacillus subtilis
Species: Bacillus subtilis subsp. subtilis
Strain: Bacillus subtilis subsp. subtilis str. 168 –
Bacillus subtilis subsp. subtilis str. SMY –
Bacillus subtilis subsp. subtilis str. JH642 –
Bacillus subtilis subsp. subtilis str. NCIB 3610 –
Bacillus subtilis subsp. subtilis str. AUSI98 –
References
- Bacillus subtilis subsp. subtilis – Taxon details on National Center for Biotechnology Information (NCBI).
This article is issued from Wikimedia. The text is licensed under Creative Commons - Attribution - Sharealike. Additional terms may apply for the media files.